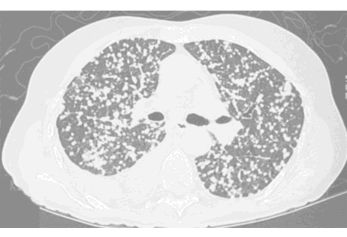

A
B
C
SHAPE - round
MARGIN - smooth
SIZE - 1-2 mm
DENSITY - can't tell on these CT windows (lung windows)
NOTE: any round lung opacity that is less than 3 cm in diameter can be called a 'NODULE'
SHAPE - irregular
MARGIN - spiculated
SIZE - 4 cm
DENSITY - can't tell on these CT windows (lung windows)
NOTE: any lung opacity that is over 3 cm in diameter or spiculated in shape must be called a 'MASS'
SHAPE - round
MARGIN - smooth
SIZE - 2.5 cm
DENSITY - contains central calcification, clearly seen on these windows (soft tissue)
NOTE: any round lung opacity that is less than 3 cm in diameter should be called a 'NODULE' - some patterns of calcification, like this, indicate a BENIGN etiology
